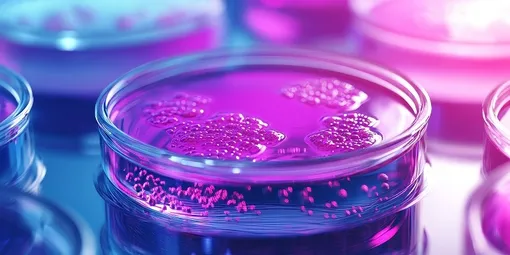
чашка Петри чашка Петри

Например, бактерии используют специальные отростки — пилеи — цепляясь ими за поверхность и подтягивая себя вперед. Или же с помощью белковых структур, которые крепятся к субстрату и позволяют микроорганизмам передвигаться на получившихся «гусеницах».
Биологический «цунами»: открыт новый способ, с помощью которого бактерии колонизируют поверхности

Авторы нового исследования изучили один из вариантов такого перемещения – роение, когда колония медленно расползается по питательной среде. Вначале ученые подумали, что для этого бактерии используют вращение жгутиков. Либо же есть какие-то другие механизмы.
Чтобы проверить гипотезу, исследователи отключили гены, отвечающие за образование жгутиков, у сальмонеллы и кишечной палочки. Ожидалось, что без них микроорганизмы не смогут двигаться. Но нет, бактерии все равно расползались.
Тогда ученые предположили, что бактерии выделяют поверхностно-активные вещества, которые позволяют им скользить, снижая трение. Затем добавили препарат Tween-80 (ПАВ) в среду, считая, что это ускорит их процесс передвижения, однако все вышло в точности до наоборот: колония остановилась.
Что помогает бактериям распространяться
А может, бактерии используют не внешние факторы, а активную ферментацию сахаров? Тогда выделенные при этом продукты могут играть роль «двигателей».
Проведенные эксперименты подтвердили: движение обусловлено переработкой сахаров и выделением соответствующих продуктов. Когда ученые «поломали» гены, ответственные за ферментацию, колония перестала расползаться вовсе. То есть анализ показал, что ферментированые продукты, например, уксусная кислота, накапливались на границе колонии и создавали осмотическое давление, вытягивая воду из среды.

С помощью специальной оптической техники исследователи увидели тонкую водяную волну высотой менее миллиметра, которая поднималась на передний край колонии. Вода, движущаяся вместе с бактериями, создавала микроскопический «накат», который подталкивал микроорганизмы вперед. Назвали этот механизм «свошинг» (от англ. «wash» – мыть, смывать).
Расползающиеся бактерии создают биопленки – важнейший фактор для распространения инфекций на медицинских имплантатах, катетерах, в ранах. И чаще всего борьбу с такими колониями ведут через блокировку жгутиков. Но поскольку новое исследование доказало, что у бактерий есть в арсенале и другой способ, пора разрабатывать новые методы профилактики инфекций.
